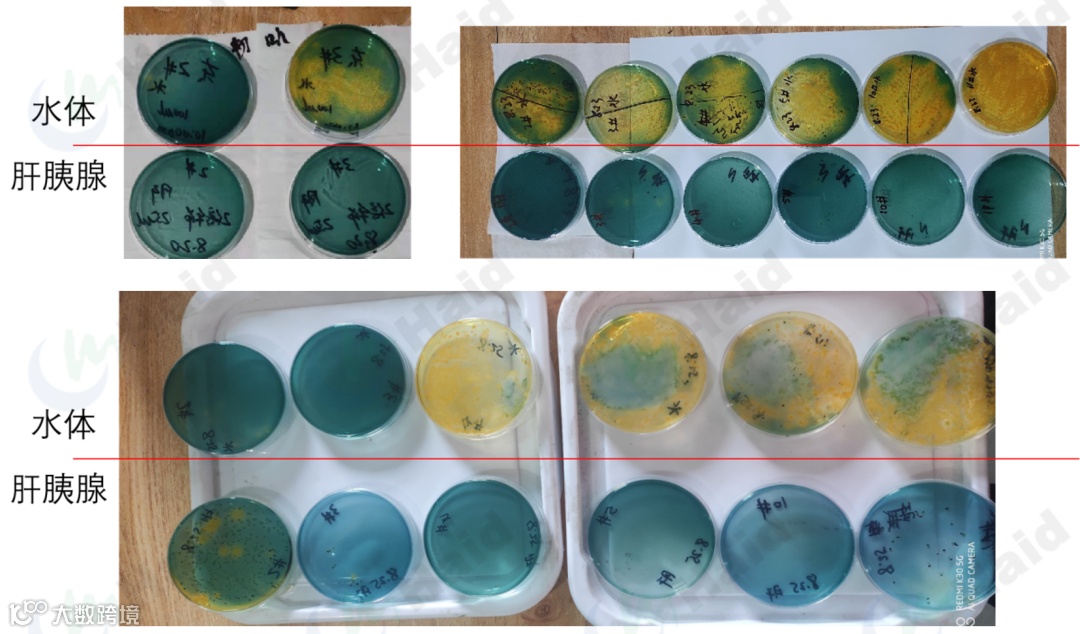
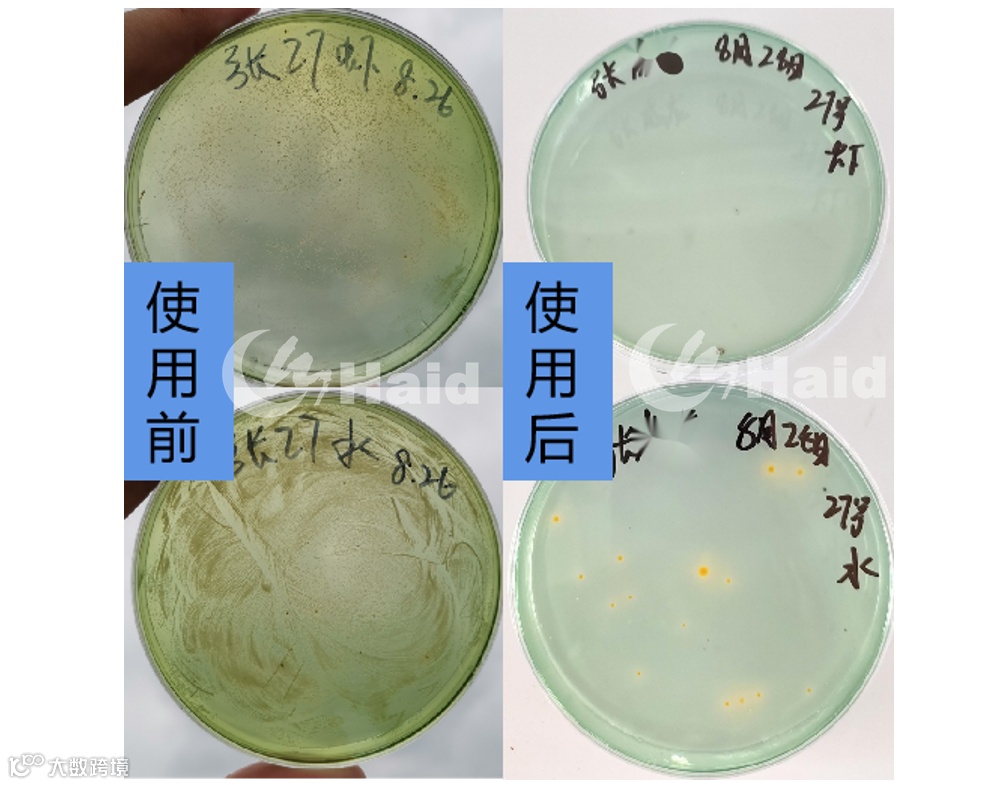

文 | 图 动保事业部 赵宗武 江苏白虾团队
2021年小棚秋虾养殖已经如火如荼地展开了,从7月底陆续放苗以来截止到8月下旬,江苏小棚放苗比例已经超过8成,预计9月初所有客户放苗结束,整体客户放苗节奏偏晚。而台风“烟花”过后,尤其是进入8月份,今年的气温和天气情况较以往也有明显的差异。首先,平均温度较去年低了4℃,感受今年的“凉意”来的更早一些;其次,阴雨天、大风天增加,异常降雨天气多发。

通过小棚水温对比也能看的出来,去年24h套水的情况下水温也在34℃以上,今年水温仅在31-32℃,早晨甚至只有28℃,部分客户已经放下了1/4的门头进行小棚保温。同时水质水色变化也有体现,今年水浓的池塘减少,但是转水、倒藻、水色发暗的棚数多,亚盐在10天左右的时间就陆续出现并飙升,这都与今年的气候密切相关。针对今年的情况,客户如何进行保苗壮苗操作呢?

一、超3万张小棚客户的选择
贝可速小棚版
针对小棚模式直放苗的体质、活力、弧菌等痛点问题,经过海大研发团队多年潜心研发,2021年秋虾推出——贝可速小棚版,针对性解决苗期的体质活力、健康发育、弧菌问题,保障虾苗平稳度过浑水期,保障养殖基础。

贝可速小棚版
① 复合天然抗氧化物——抗应激
添加大量虾青素、EPA等活性营养物质,提升虾苗抗应激能力。
② 海洋源功能多糖多肽——提活力
海洋多肽是海洋生物重要的生理调节物,激活虾体内酶系,增强和发挥虾体生理活性;海洋多糖减少毒性,清除体内自由基,提升虾仔活力。
③ IAB昆虫蛋白/抗菌肽——双管齐下抑弧菌
添加多种活性清除弧菌抗菌肽,有效预防弧菌侵袭虾体;同时贝可速低温制粒工艺,大大提高抑制弧菌活性功能物质利用效率。
④ 发酵中草药——发动内驱强免疫
充分激活肝胰腺分泌免疫酶,吞噬病原组织;增密肠绒毛,为防弧菌侵袭,建立天然免疫屏障。
截止到目前,江苏小棚区域客户备货近10000桶,覆盖面积超3万张棚,那客户应用效果到底如何呢?
二、秋虾贝可速应用实例
高产基础要打牢,顺畅加料是基础

贝可速投喂、生长模型
都知道秋虾要往后拖,但拖的前提是得有基础投喂量(存塘产量)和基础规格,今年的气候下市场整体加料、转料要偏慢一些,虾苗生长较以往也会慢一些,客户对生长和投喂有一定的要求。持续跟进贝可速的池塘池投喂量可以看到,贝可速1号、2号开口过料顺畅,衔接03料过渡顺畅,投喂到21天贝可速组干料日投喂量达6斤;虾苗体长打样差异显示,贝可速组比粉料组长速快5%。

虾苗开口摄食差异
健康发育体质强,贝可速虾苗就是靓
虾苗评判标准分级

肝脏肠道评判标准

虾苗前期摄食充足的营养才能表现出强健的体质。从跟进客户反馈上看,同样水质情况下,投喂贝可速虾苗体色透亮、麻点少,而粉料虾苗体色发黄、麻点多。更明显的在于虾苗活力表现上,贝可速虾苗弹跳有力、活力四射,而粉料虾苗表现的“软趴趴”。可以看出贝可速中的活性成分被虾苗消化吸收后宏观表现上呈现出差异。

虾体色显性对比图
针对性的营养添加能更好的帮助虾苗肝胰腺、肠道发育。对比肝白膜表现情况在客户端表现差异比较大,主要是区域水环境的差异,在环境相近的情况,投喂贝可速虾苗的白膜出现时间比投喂粉料的虾苗早2-3天,同时白膜的清晰度和肝脏包被程度更高,表明吸收营养更匹配、发育更好。

生长发育差异(评价指标越接近1越优质)
通过持续镜检投喂贝可速和粉料虾苗的肝小管发育、肠道健康情况,贝可速虾苗的肝小管发育更完善,轮廓清晰圆润无褶皱,脂肪颗粒和内容结构细胞更充实,表明肝胰腺贮存营养丰富,转肝基础好。贝可速肠道韧性强,色素更凝聚,肠道能够健康发育。

发育显微对比图
肠道健康消化好,后期加料有保障
小棚前期投喂粉料、破碎易溶失,而虾苗摄食旺盛,容易吃到死藻、底泥杂质等有害物质,出现长便、拖便的情况,这都是肠炎的早期症状。持续跟进使用贝可速的客户情况,90%客户粪便短粗成型,粉料黏便长便发生率4成以上。进一步镜检肠道色素发现,贝可速客户肠道色素凝聚,多为1级肠道,基本都在2级肠道以上,而粉料肠道易出现肠道色素弥散,甚至出现4级肠道,后期难加料。

粉料粪便、贝可速粪便

肠道色素差异
弧菌防控做得好,后期风险低不少
养殖基地跟进(水体弧菌爆表、个别体内弧菌少量)
通过海大养殖基地的持续跟进,在水体弧菌爆表的情况下,虾苗体内弧菌依旧为0,能够有效抵御护具侵袭,到了扫浑的阶段水体黄绿弧菌含量出现明显飙升,体内弧菌依旧可控。在市场养殖户端也出现了相似的情况,浑水期弧菌出现飙升,体内弧菌超标,通过调水操作+拌服贝可速3号,很好的控制住了体内弧菌,而粉料组虾体依旧出现弧菌。

客户端跟进
通过大量检测使用贝可速、粉料客户的水体和虾体弧菌,44份样本结果显示:


弧菌结果差异展示
三、浑水期弧菌问题预防
随着养殖的进行,水体逐渐“扫浑”,进入小棚养殖中最重要的关卡——浑水期。通过海大技术团队的走访调研和基地数据跟进,从数据层面上为大家做简要解读。

投喂模型、养殖阶段、水色变化关系
密度6.5w/棚,在累计投喂量130斤,预计存塘量200斤(前期料比0.7)左右的时候水体开始扫浑,根据底质、水体肥度等环境因素因地而异。在这个阶段,水体藻相开始发生转变,藻类丰度快速下降,硅藻占比逐步提升至50%;同时,亚盐开始飙升直至爆表,可以看出这是一个水体发生剧烈变化的阶段。

水体藻相变化情况

水质亚盐情况
而在小棚这种高盐高密度的基础下,这个阶段极易滋生弧菌。经过跟踪小棚总菌和弧菌的变化规律,浑水期阶段总菌数量减少、弧菌数量增加是弧菌发病的内因。

因此,浑水期弧菌问题的防控在于外源肥水,提高藻类丰度、改善水质代谢通路,稳定水质;同时补菌提高总菌数量,抑制弧菌爆发。内源服用功能性物质,提高虾仔免疫力,预防弧菌侵袭。
贝可速3号特别添加多种活性抗菌肽,强力清除虾苗体内弧菌;同时贝可速低温制粒工艺,大大提高抑弧菌活性功能物质的利用效率;核心发酵中草药配方,激活虾体内源免疫力,建立天然免疫屏障,有效预防弧菌侵袭。
使用方法
预防拌喂,1斤/餐/天,安全度过浑水阶段;处理问题,50%拌喂持续拌喂,同时搭配调水操作保障外环境稳定。

海大服务团队将全天候在线,为大家做好检测服务,助力秋虾养殖成功!
海大农牧
接地气的水产一线技术
长摁二维码,即刻关注

